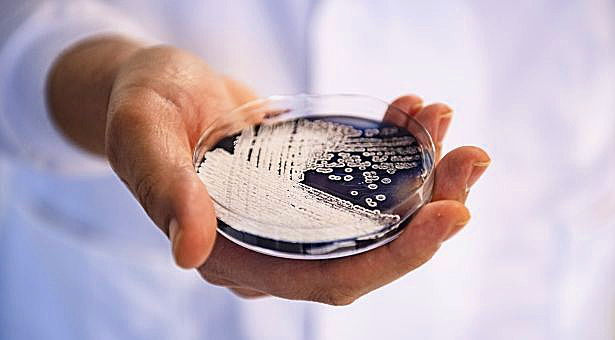
BLOG - How, and why, do plants and microbes interact?

Microbes have evolved over the past 3.5 billion years to survive in diverse habitats, including in/on plants. But whilst some are beneficial, others can cause devastating diseases <a href="/micronorwich/">Centre for Microbial Interactions</a>

okt.to/318Qak

Harnessing Biosynthesis For Food and Health
@hbioisp
Harnessing Biosynthesis For Sustainable Food and Health (HBio) Strategic Research Programme at the @JohnInnesCentre Funded by @BBSRC
ID: 864832844576808962
https://www.jic.ac.uk/research-impact/our-strategic-research-programmes/harnessing-biosynthesis-for- 17-05-2017 13:19:52
2,2K Tweet
523 Takipçi
285 Takip Edilen


The John Innes Centre and other institutes Norwich Research Park have joined over 40 leading organisations in signing a joint letter calling on the Government to protect R&D funds in the #autumnbudget sciencecampaign.org.uk/analysis-and-p… CaSE Earlham Institute Quadram Institute


📺 The Centre for Microbial Interactions Centre for Microbial Interactions was on ITV News Anglia last night, featuring researchers from across Norwich Research Park Park Watch from 07:25 ➡️ buff.ly/3YhFYnF John Innes Centre UEA Earlham Institute The Sainsbury Laboratory Norfolk and Norwich University Hospitals


This 👉 forms.office.com/Pages/Response… Plant-Microbiome Interaction Symposium in the John Innes Centre 10-11 February 2025 (and also a job market for those aspiring PIs-to-be on the topic)


VACANCY - We're recruiting a Director to lead our world-renowned, independent, international centre of excellence in plant science, genetics and microbiology. Please share and apply: okt.to/kURnfW Closing date - 22 November 2024 Norwich Research Park


A very interesting read! NorfolkPlantSciences The Purple Tomato Story; From Laboratory Bench to the Consumer | ACS Food Science & Technology pubs.acs.org/doi/10.1021/ac…

Don't miss the chance to hear from Keynote Speaker Anne Osbourn atthe Genetic Engineering for a Sustainable Future. Submit your abstracts for a chance to give a short talk. Applications close on Nov. 20th, 11:59pm MST. hubs.la/Q02X0_Z-0 #KSSustainFuture25 John Innes Centre


Apply TODAY for the John Innes Foundation Rotation PhD Programme 🪴 This prestigious 4-year #PhD programme trains graduate students in Plant and Microbial Sciences at the John Innes Centre and The Sainsbury Laboratory Closing date - 14 November 2024 More info: okt.to/nCW6gX

In their Perspective, Anne Osbourn and colleagues John Innes Centre argue that #plants harbor a vast array of as yet undiscovered chemistry, highlighting the potential to harness this capability at unprecedented scale for drug #discovery and development. plos.io/3YUYofR


BLOG - How, and why, do plants and microbes interact? Microbes have evolved over the past 3.5 billion years to survive in diverse habitats, including in/on plants. But whilst some are beneficial, others can cause devastating diseases Centre for Microbial Interactions okt.to/318Qak

NEWS - A new piece in the grass pea puzzle – updated genome sequence published An international research collaboration has completed the most detailed genome assembly to date of grass pea (Lathyrus sativus). okt.to/FQAxYR Norwich Research Park



🆕 We are delighted to announce the appointment of Professor Daniel Figeys as our new Director and Chief Executive. buff.ly/40H5BRN




📣 Apply TODAY for our International Undergraduate Summer School 2025 🌎 A unique opportunity for global #undergraduates to spend 8 weeks at our internationally renowned research centre on Norwich Research Park 🗓️ Deadline: 16 January 2025 Find out more: okt.to/UCq0dp
